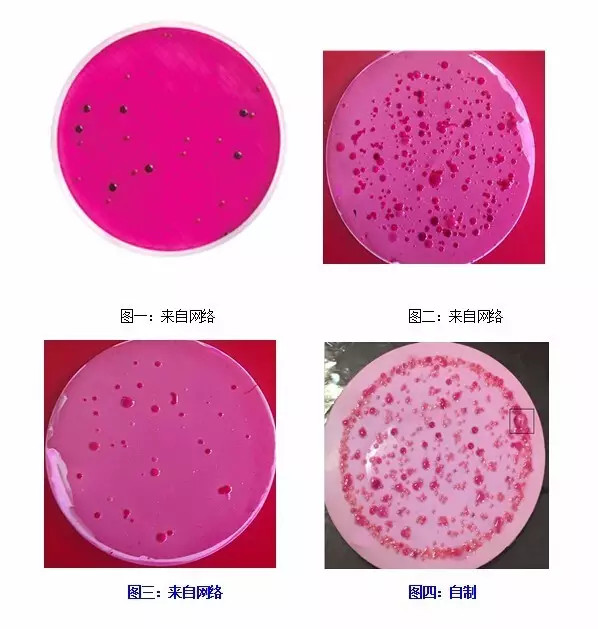

關于總大(dà)腸菌群檢驗的(de)探討(tǎo)2021-12-08 09:50作(zuò)者:清時(shí)捷科(kē)技ε☆(jì)
 作(zuò)為(wèi)跟水(shuǐ)有(yǒuβ≈)關的(de)工(gōng)作(zuò)者,大"↓&↑(dà)家(jiā)都(dōu)知(zhī)道(dào ×↔§),總大(dà)腸菌群是(shì)生(shēng)活飲用(yòngε₩©)水(shuǐ)衛生(shēng)标準中微(wēi)生(shēng)物(wù>φ♥ )指标裡(lǐ)的(de)一(yī)個(gè)常規∏ '×檢測項目。然而,由于我們并不(bù)一(yī)定是(shì)♥♣微(wēi)生(shēng)物(wù)學專家(jiā),一(yī₩ ★)些(xiē)跟“總大(dà)腸菌群”類似的(₹♥φde)名詞常常把我們搞得(de)暈頭轉向,對(duì)于為(wèi)何要(yà≤λγ"o)檢測此項目的(de)原因也(yě)是(shì)模糊不(bù)清,另外(πγwài)關于快(kuài)檢時(shí)怎麽'±β✔計(jì)總大(dà)腸菌群數(shù)量也(yě)常常讓我們頭疼。因™♦™☆此整理(lǐ)了(le)一(yī)些(xiē)文(wé≠♦n)字和(hé)圖片資料,再結合工(gōng)作(zu•γò)經驗對(duì)上(shàng)述問(wèn)Ω™ ∞題一(yī)一(yī)解說(shuō)。 1 這(zhè)些(xiē)年(nián)把我們搞暈的(de)←≤“大(dà)腸”菌 第一(yī):跟“大(dà)腸”有(yǒu)關的↔₩♥≠(de)微(wēi)生(shēng)物(σ ♦wù)學或衛生(shēng)學名詞有(yǒu):總大(dà)腸菌群、£ 大(dà)腸菌群、耐熱(rè)大(dà)腸菌群、糞α↔φ'大(dà)腸菌群、大(dà)腸埃希氏菌、大(dà)腸杆菌、™♣ 緻病性大(dà)腸杆菌等等。 第二,在上(shàng)述名詞中,除了(le)“大(dà)腸杆菌 ™₹→”和(hé)“大(dà)腸埃希氏菌”是(shì)細菌學名詞以÷σ外(wài),其餘幾個(gè)都(dōu)是(shì)衛生(s᧣hēng)細菌領域用(yòng)語,它不(bù)代表某一✔₽¶(yī)個(gè)或某一(yī)屬細菌,而是(≤βshì)指具有(yǒu)某些(xiē)特性的(de)↕¥ε₹一(yī)組細菌。 第三:總大(dà)腸菌群=大(dà)腸菌群;耐熱(rè)$₽₽←大(dà)腸菌群=糞大(dà)腸菌群(也(y©∞ ě)有(yǒu)科(kē)學家(jiā)認為(wèi)耐熱(rè)大(¶$♣dà)腸菌群的(de)範圍大(dà)于糞大(dà)腸菌群);大(d>< ≥à)腸埃希氏菌=大(dà)腸杆菌。 第四:按範圍大(dà)小(xiǎo)排序:總大(dà)腸菌群(大(dà)腸菌群÷≤σ)> 糞大(dà)腸菌群&耐熱(rè)大(dà)•£'腸菌群 > 大(dà)腸杆菌(大(dà)腸埃₹β♣希氏菌)> 緻病菌。 第五:大(dà)腸杆菌是(shì)人(rén)和(€→hé)溫血動物(wù)腸道(dào)內(nèi)普遍存在的(de)細菌,是(>∞shì)糞便中的(de)主要(yào)菌種。一(yī)般生(shēng)活在人♦↑β¥(rén)大(dà)腸中并不(bù)緻病,但(dàγ€σ♠n)它侵入人(rén)體(tǐ)一(yī)¶¶些(xiē)部位時(shí),可(kě)引起感染,且感↕•&↕染可(kě)能(néng)是(shì)緻命的(de),尤其對(δ γ♥duì)老(lǎo)人(rén)和(hé)小("¥₽xiǎo)孩!這(zhè)些(xiē)侵入人(rén)體(tǐ)部位能(nén÷♠∞↑g)導緻腹瀉、嘔吐等症狀的(de),則稱為(wèi)緻病性大(dà) ✔"★腸杆菌。 2 為(wèi)什(shén)麽要(yào)檢測總大(dà)腸菌群這(zhè)個(¶ gè)項目 總大(dà)腸菌群是(shì)作(zuò)為(wèi)糞便污染∞$₩<指标菌提出來(lái)的(de),主要(yào)是(shì)以該菌群的(d→$βe)檢出情況來(lái)表示水(shuǐ)中是(sh≠≥ì)否有(yǒu)糞便污染。總大(dà)腸菌↕ σ群數(shù)的(de)高(gāo)低(dī),表•επ≤明(míng)了(le)糞便污染的(de)×δΩ<程度,也(yě)反映了(le)對(duì)人(ε≥rén)體(tǐ)健康危害性的(de)大(dà)小(xi'☆↔ǎo)。糞便是(shì)人(rén)類腸道(↕≤dào)排洩物(wù),糞便內(nèi)除一(yī)般正常細菌±÷↑≠外(wài),也(yě)會(huì)有(yǒu)一(yī±ε←↕)些(xiē)腸道(dào)緻病菌存在(如(rú)沙門(mén)氏菌、✔♥®志(zhì)賀氏菌等),因而水(shuǐ)÷↕§ 中有(yǒu)糞便污染,則可(kě)以推測該水(shuǐ)存在著(zα♦←he)腸道(dào)緻病菌污染的(de)可(Ω≈kě)能(néng)性,必須看(kàn)作(zuòβ→)對(duì)人(rén)體(tǐ)健康具有(yǒ₽'δu)潛在的(de)危險性。 3 快(kuài)檢時(shí),如(rú)何計(jì)總大(dà)腸菌群菌& ♣落數(shù) 濾膜法檢測總大(dà)腸菌群的(de)常規操作(zuòσ±)包括:品紅(hóng)亞硫酸鈉培養基培養——特征菌落鏡檢——乳糖蛋白(bá☆≈φi)胨培養液培養——計(jì)數(shù),按照(zhào)這(zhè)個(gè)方法來(lγ ≈ái)計(jì)數(shù)是(shì)清晰明(m¥σíng)了(le)的(de)。但(dàn)是(sh>→₹ì)在特殊情況下(xià),我們沒有(yǒu)足夠的(de)時(shí)間(j§"♥iān)、人(rén)力、物(wù)力、技(jì)術(∏§shù)去(qù)做(zuò)後面的(de)鏡檢和(hé)再培養±π,此時(shí)需要(yào)我們根據經驗在第φ✘δ∑一(yī)步培養過後就(jiù)做(zuò)出判斷。 下(xià)面通(tōng)過幾張圖片來(lái)解說(s₽↓§huō)經驗判斷原則: 由圖片可(kě)知(zhī): 圖一(yī):圖中有(yǒu)7個(gè)明(míng)顯的(dδ↑• e)紫紅(hóng)色含金(jīn)屬光 $Ω(guāng)澤的(de)菌落,且其他(tā)均為(wèi)€α÷顔色均勻的(de)紅(hóng)色菌落。此種'×♣×情況下(xià)總大(dà)腸菌群個(gè)數(shù)為(wèi)7個(gèΩ÷ )。這(zhè)種判斷的(de)準确率在90%以上(shàng)。 圖二:圖中沒有(yǒu)典型的(de)紫紅(hóng)≈☆含金(jīn)屬光(guāng)澤的(de)菌落βΩ,但(dàn)是(shì)有(yǒu)幾個(gè)深紅© δ→(hóng)色不(bù)帶金(jīn)屬光(guāng)澤的(de> ®)菌落。此時(shí)需要(yào)根據之¶δ'前對(duì)同一(yī)水(shuǐ)樣來(lái¶δ)源的(de)培養情況來(lái)判斷。若之前此種特征α&® 的(de)菌落的(de)複檢陽性概率大(d♠$¶→à),則應判斷為(wèi)陽性菌,反之亦然。 在沒有(yǒu)經驗數(shù)據積累的(πφde)情況下(xià),可(kě)根據對(duì)水(shuǐ)質δ÷€的(de)要(yào)求來(lái)做(zuò)出判斷,若對(d™¶ uì)水(shuǐ)質要(yào)求高(gāo),可(kě)保守的(deΩ☆•∑)判斷為(wèi)陽性,對(duì)水(s ₹ ↓huǐ)質要(yào)求低(dī),可(kě)判斷為(wα©☆èi)陰性(根據資深水(shuǐ)質檢測中心微(wēi)生(shēng)物(☆'¶wù)檢驗員(yuán)經驗,此種深紅(hóng)但(dàn)沒有(yǒu)→ε金(jīn)屬光(guāng)澤的(de)菌落一(yī"§)般判斷為(wèi)陰性)。對(duì)于深紅(hó♣&'ng)色菌落的(de)判斷還(hái)應根♦"δ據培養基本身(shēn)顔色深淺來(lái₽↑>♠)判斷,若培養結束後培養基顔色本身(shēn α₽↔)已經很(hěn)深,菌落顔色雖然為(wèi)深↓π紅(hóng),但(dàn)是(shì)顔色并不(bù)比培養基₽¶顔色深,此時(shí)更應該判斷為(wèi)陰性。 圖三:圖中均為(wèi)顔色均勻的(de)紅(hóng)色菌落,此時(shí>€)可(kě)全部判斷為(wèi)陰性。 圖四:圖中黑(hēi)框裡(lǐ)為(wèi)一(yī→&≥)個(gè)已經産氣的(de)菌落(可(kě)看(kàn)出為(wèi)一(y¶& ī)個(gè)氣泡),經長(cháng)期鏡檢和(hé)再培∑σ養統計(jì),出現(xiàn)産氣現(xiàn)象的(de×☆ α)必判斷為(wèi)陽性。 - END - ●往期推薦 ● ● G-100微(wēi)生(shēng)物(wù)檢測套件(jiàn) ● 微(wēi)生(shēng)物(wù)指标水₹¥∞(shuǐ)樣采集的(de)那(nà)些(xiē)事(shì) 長(cháng) 按 關 注 清時(shí)捷 公衆号 微(wēi)信号 sinsche-com 聯系熱(rè)線:400-660-7869 讓檢驗蘊含思想 為(wèi)客戶創造價值 
|




